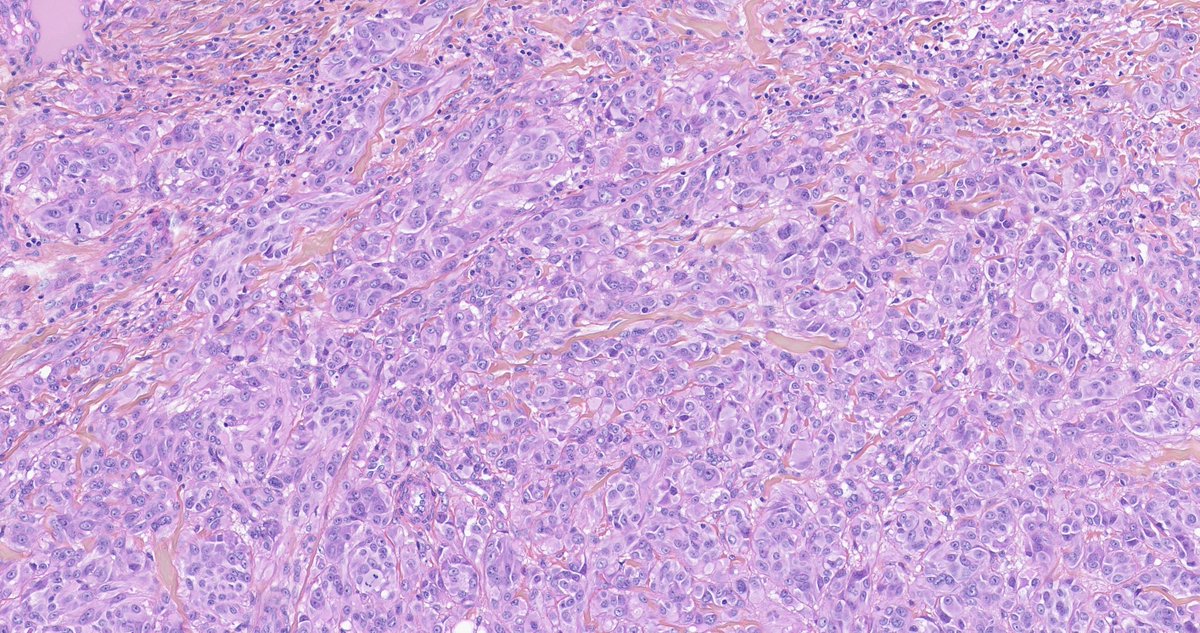
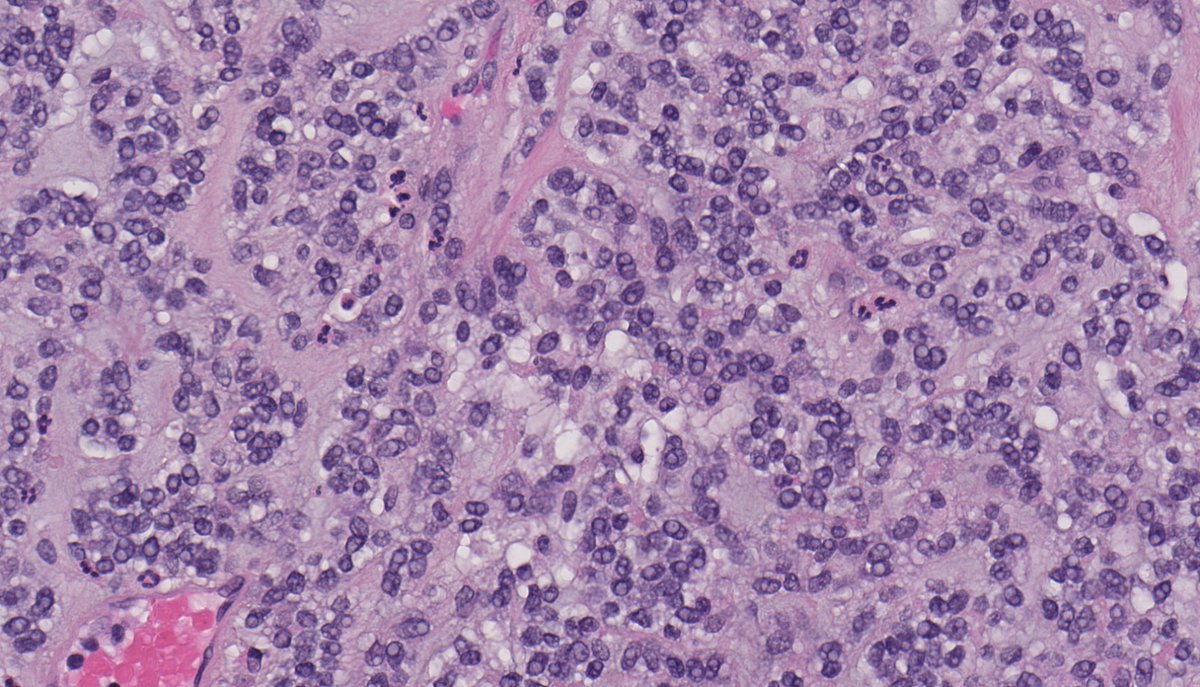
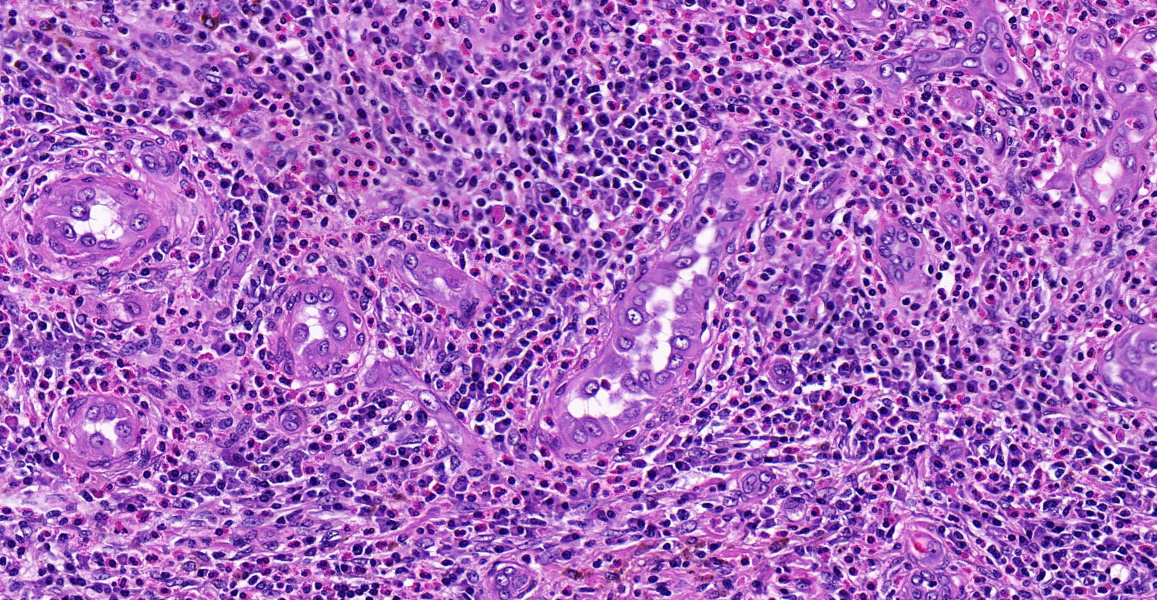

Celestine Trinidad, MD
@celestrinmd
Pathologist from the Philippines, with a special interest in Bone and Soft Tissue, Breast Pathology, and Dermatopathology. Also a nerd, and proud of it!
ID: 1190278162728374273
01-11-2019 14:43:51
2,2K Tweet
1,1K Followers
551 Following












Spitz series 4/5 from the consult files of Arnaud de la Fouchardiere MD, PhD Multinucleated melanocytes, with moderate atypia, arranged in a sheet-like growth pattern in this MAP3K8-fused Spitz tumor #dermpath #dermatology

Overseen today University of Maryland Medical Center in the #cytology area Happy Valentine's day #pathtwitter